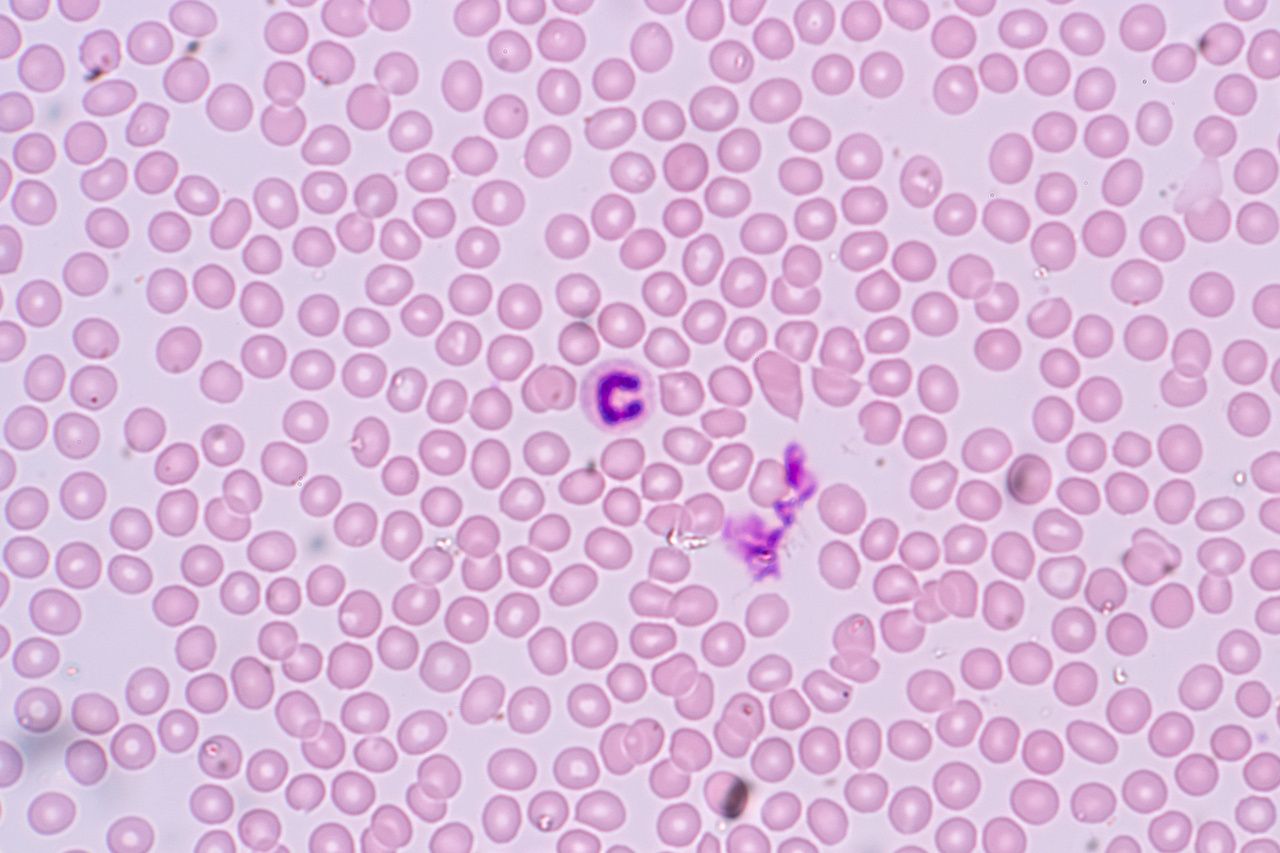

Hematology
Latest News
CAR T-Cell Therapy and Beyond: Off-the-Shelf Therapies Among Innovations at ASH 2019
Latest Videos

CME Content
More News

Research has shown that fedratinib favorably impacts health-related quality of life for patients with myelofibrosis across the board, said Ruben Mesa, MD, director of UT Health San Antonio MD Anderson Cancer Center.

Immunotherapy continues to be increasingly used for treating multiple myeloma (MM) with a recent report providing an overview of monoclonal antibodies (mAbs) currently approved for treating MM, as well as, compounds that are under investigation.

As a result of the opioid epidemic, there have been instances where it has been difficult to treat patients with pain related to their sickle cell disease because of new policies in place intended to curb addiction and overdoses, said C. Patrick Carroll, MD, director of psychiatric services, Sickle Cell Center for Adults, associate professor of psychiatry, Johns Hopkins Medicine.

In research presented at the 61st American Society of Hematology Annual Meeting and Exposition, Abby Statler, PhD, MPH, MA, research associate, Cleveland Clinic, and her colleagues found that African Americans with acute myeloid leukemia (AML) may be excluded from clinical trials due to renal dysfunction, despite it having no impact on AML outcomes.

An executive with Jazz Pharmaceuticals said the ability to extend survival time in patients with secondary AML, and potentially offer them improved odds for transplant is an advance over traditional chemotherapy.

The terminology for smoldering myeloma has been around for decades, but more discussion over what it means and who it really applies to is needed, said C. Ola Landgren, MD, PhD, professor of medicine and chief of the Myeloma Service at Memorial Sloan Kettering Cancer.

The company presented updated phase 1 results for a revamped version of bb2121 that point to sustained responses for patients with relapsed/refractory multiple myeloma.

As more patients with cancer survive, the risk of cardiac complications due to the effects of therapies has become a concern to oncologists and cardiologists alike.








This week, the top managed care stories included the White House seeking a truce between CMS Administrator Seema Verma and HHS Secretary Alex Azar; Sanofi will shift its focus from diabetes to cancer drugs; results highlight real-world evidence of chimeric antigen receptor T-cell therapies.

Although survival rates for multiple myeloma have improved as treatment options have increased, the disease remains incurable, and many patients stop current agents such as lenalidomide or bortezomib due to toxicity. Results of CANDOR involving a triple therapy were presented Tuesday at the 61st American Society of Hematology Annual Meeting and Exposition in Orlando, Florida.

Treating venous thromboembolism (VTE) in patients can be tricky due to greater risks of major bleeding episodes and recurrent VTE.
The findings show the importance of preventing bone disease in multiple myeloma (MM), the authors said.

The FDA Monday granted accelerated approval to voxelotor (Oxbryta) for the treatment of sickle cell disease in adults and pediatric patients 12 years or older.

With their ongoing study, the authors also hope to show the physical effect of exercise on function, quality of life, pain, and bone disease.

Tumor inflammatory response is significantly associated with poor prognosis in patients with multiple myeloma.

After saying he would back a ban on flavored vapes, President Trump now says he wants to study the issue more; the FDA approved Novartis’ crizanlizumab (Adakveo) as both monotherapy and in combination for patients 16 years or older with sickle cell disease; the Federal Trade Commission will allow Bristol-Myers Squibb to purchase Celgene for $74 billion in cash and stocks.

There are substantial reductions in income over a lifetime for patients with sickle cell disease owing to early mortality, according to a new study that seeks to provide a better understanding of the condition from both the patient point of view as well as a societal point of view.

Researchers aim to eliminate leukemia stem cells safely.




















































